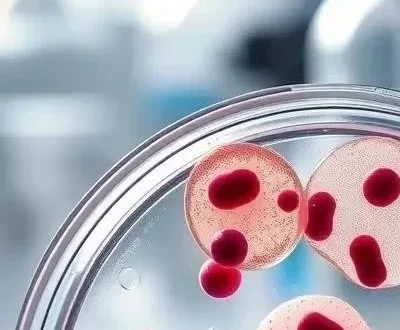
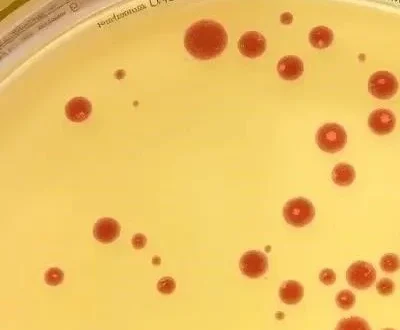

таурин
- складывается из условий хранения при перевозке на удобную дату и время.
Здоровье и красота
Полезные статьи о красоте и уходе за собой: полезные уходовые процедуры, советы косметологов. Обзор косметики, использование косметических средств. Советы по здоровому образу жизни и секреты молодости
Ищешь надежную контрацепцию в 2026? Узнай об эффективных способах планирования семьи, индексах Перля и современных тенденциях в репродуктивном здоровье. Будь уверена в своем выборе!
Эндометриоз – коварное женское заболевание. Узнайте о причинах, симптомах и современных методах лечения эндометриоза, чтобы вернуть себе здоровье и комфорт!
Чувствуете усталость и выгорание? Узнайте, как сохранить эмоциональное здоровье женщины в современном мире, обрести внутреннюю гармонию и жить полной жизнью!
Хочешь быть здоровой, красивой и энергичной в 2026? Узнай о самых эффективных физических упражнениях для женщин, разработанных с учетом особенностей организма. Начни свой фитнес-путь прямо сейчас!
Мучает токсикоз во время беременности? Узнайте причины, симптомы и самые эффективные способы облегчить тошноту и рвоту. Советы для будущих мам!
Узнайте все об эрозии шейки матки в 2026 году! Современные методы лечения, эффективная профилактика и ответы на важные вопросы. Заботьтесь о своем здоровье!
Узнайте всё об эндометрите в 2026 году! Симптомы, современные методы лечения и эффективная профилактика воспаления матки. Сохраните женское здоровье!
Болит живот и проблемы с пищеварением? Узнайте о симптомах, диагностике и современных методах лечения эндометриоза кишечника. Не терпите дискомфорт!
Узнайте все о цервиците: симптомы, причины, современные методы лечения и эффективная профилактика воспаления шейки матки. Сохраните женское здоровье!
Узнайте всё о хламидиозе в 2026 году! Симптомы, современные методы лечения и эффективные способы профилактики. Защитите своё здоровье и будьте уверены в себе. Хламидиоз – это реально победить!
Узнайте все об уреаплазмозе: скрытые симптомы, точная диагностика и современные методы лечения. Защитите свое здоровье и избежите осложнений! Уреаплазмоз – это серьезно.
Беспокоит трихомониаз? Узнай о симптомах, современных методах диагностики и лечения в 2026 году. Забудь о дискомфорте и верни себе здоровье!
Узнайте все о склерокистозных яичниках: симптомы, причины, диагностика и современные методы лечения. Верните здоровье и уверенность в себе!
Узнайте всё о сифилисе в 2026 году: от ранних симптомов до современных методов лечения. Актуальная статистика по Москве и России. Не игнорируйте **сифилис** – будьте здоровы!
Заметили признаки сальпингита? Узнайте о симптомах, современных методах лечения и эффективной профилактике воспаления маточных труб у наших гинекологов в 2026 году!
Узнайте о коварном раке яичников: первые признаки, точная диагностика и передовые методы лечения в 2026 году. Не игнорируйте свое здоровье!
Узнайте все о раке шейки матки: от ранних симптомов до современных методов лечения и эффективной профилактики. Повысьте свои шансы на выздоровление!
Узнайте о симптомах рака молочной железы, стадиях развития и современных методах лечения. Не игнорируйте сигналы организма – ранняя диагностика спасает жизни! Подробная информация здесь.
Беспокоит здоровье? Узнайте о симптомах рака матки, современных методах диагностики и лечения. Важная информация для женщин любого возраста!
Заметили изменения во влагалище? Рак вульвы – это серьезно, но своевременная диагностика и современные методы лечения дают шанс на выздоровление. Узнайте больше!
Не игнорируйте тревожные сигналы! Узнайте о симптомах, диагностике и лечении рака влагалища, чтобы сохранить ваше женское здоровье. Раннее обращение спасает жизнь.
Узнайте, как сохранить беременность при преждевременных родах! Важные советы, причины, риски и современные методы лечения для здоровья вас и ребенка.
Узнайте всё о ВПЧ в 2026 году: симптомы, современные методы лечения и эффективная профилактика. Защитите себя и своих близких! Обновленная информация от экспертов.
Узнайте все о невынашивании беременности: от ранних признаков и возможных причин до методов диагностики и психологической поддержки. Важная информация в 2026 году!
Беспокоит молочница? Узнайте все об эффективном лечении кандидоза в 2026 году! Избавьтесь от зуда, раздражения и неприятных выделений – советы и рекомендации здесь!
Беспокоит молочница во время беременности? Узнайте о безопасных методах лечения и эффективной профилактике в 2026 году! Защитите себя и малыша.
Микоплазмоз – коварная инфекция, передающаяся половым путем. Узнайте о симптомах, современных методах диагностики и эффективном лечении микоплазмы. Не игнорируйте свое здоровье!
Узнайте всё о мастите в 2026 году! Симптомы, современные методы лечения и эффективная профилактика воспаления молочной железы. Защитите своё здоровье!
Беспокоит молочница? Узнайте все о симптомах, причинах и самом эффективном лечении кандидозного вульвовагинита в 2026 году. Советы по профилактике!